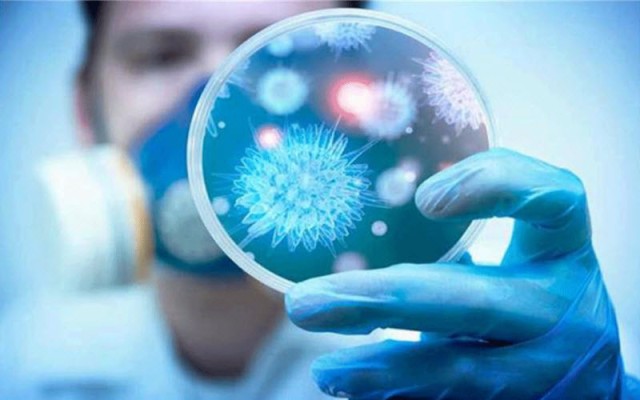
"الصحة العالمية": بدأنا نتعرف على صورة أوضح حول تطور انتشار كورونا

تلقي تداعيات انتشار كورونا بظلالها على أسعار الذهب والنفط في الآونة الأخيرة، ففي الوقت الذي يُحقق فيه المعدن الأصفر قفزات سعرية بالتزامن مع تفشي الفيروس عالمياً، نجد الذهب الأسود (النفط) يتراجع بفعل الأخبار السلبية التي ترد عن صعوبة التنبؤ بالوضع الحالي لمكافحة الفيروس القاتل.
ارتفع الذهب أكثر من 2% اليوم الاثنين، ليسجل أعلى مستوى منذ فبراير شباط 2013، إذ فاقم ارتفاع حالات الإصابة بفيروس كورونا في عدة دول غير الصين المخاوف من تضرر النمو الاقتصادي العالمي مما حفز الإقبال على المعدن الأصفر الذي يُعتبر ملاذا آمنا.
وارتفع الذهب في المعاملات الفورية 1.2% إلى 1663.06 دولار للأونصة وكان قد سجل في وقت سابق من الجلسة 1678.58 دولار.
وفي التعاملات الآجلة في الولايات المتحدة ارتفع الذهب 1% إلى 1665 دولاراً.
في المقابل، انخفضت أسعار النفط ما يزيد عن 2% يوم الاثنين، في الوقت الذي تسبب فيه الانتشار السريع لفيروس كورونا في عدة مواقع خارج الصين في قلق المستثمرين بشأن تأثر الطلب سلباً.
وتراجع خام برنت 1.42 دولار أو ما يعادل 2.4% إلى 57.08 دولار للبرميل، لكنه مرتفع عن المستوى المتدني البالغ 56.53 دولار الذي لامسه في وقت سابق.
وهبطت العقود الآجلة للخام الأمريكي 1.26 دولار أو 2.4% إلى 52.12 دولار.
وتلقت أسعار النفط بعض الدعم بعد أن قال مسؤولون محليون بقطاع الصحة في الصين اليوم إن 4 مقاطعات قلصت إجراءات الطوارئ المتعلقة بالاستجابة للفيروس.